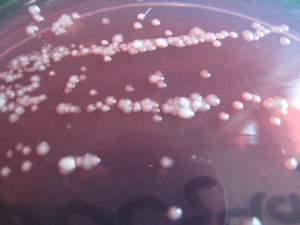
超級細菌之王
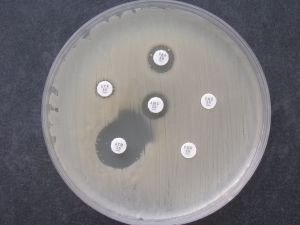
碳青黴烯類耐藥肺炎克雷伯菌

概述
碳青黴烯類耐藥肺炎克雷伯菌
碳青黴烯類耐藥肺炎克雷伯菌歷史發現
1、CRKP並不是最近才出現的,十年前人們就已經在討論這種細菌了。它們第一次被發現是在美國北卡羅來納州,當時這種細菌在曼哈頓引起嚴重的感染。2、雖然最近加州出現CRKP蔓延的勢頭,這種細菌在那裡也已經存在很長時間了。只是因為爆出感染率升高的訊息,人們才關注到它。
性能特點
碳青黴烯類耐藥肺炎克雷伯菌
碳青黴烯類耐藥肺炎克雷伯菌2、CRKP的獨特之處在於它對碳青黴烯類抗生素具有強大的抵抗力,而碳青黴烯類抗生素不久前被稱為“人類抵抗細菌的最後一道防線”,之前出現對其他所有抗生素都耐藥的細菌感染時,人們就會拿出碳青黴烯類這個殺手鐧。而現在碳青黴烯類對CRKP也束手無策了。
3、CRKP可分泌能夠水解碳青黴烯類抗生素的酶。最可怕的是CRKP能夠把自己的耐藥性傳遞給其他細菌。CRKP接觸其他已經多重耐藥的細菌後,含耐藥基因的DNA片段就會從CRKP轉移到這些細菌的菌體。事實上已有此類報導因接受了CRKP的耐藥基因而對碳青黴烯類耐藥的大腸桿菌引起了院內感染。
4、即使沒有耐藥性的革蘭氏陰性細菌仍然很難對抗,因為革蘭氏陰性細菌比革蘭氏陽性細菌有更嚴密的天然屏障。比如,它們有兩層外膜,藥物要發揮抗菌作用,必須首先穿透兩個單獨的屏障。革蘭氏陰性細菌還有各種外派泵,能夠泵出已進入菌體內的抗生素等異物。
防治措施
1、CRKP感染主要發生在醫院內,但人們不得不到這些場所去。他們要進行實驗室檢查,確定感染微生物的種類。然後採取規定的隔離措施:隔離感染者,醫護人員穿戴防護服、嚴格清洗消毒。大型醫療單位都使用這樣的工作流程。2、耐藥細菌的可怕之處在於它們傳播的過程中會發生變異,所以包括CRKP在內的很多超級細菌只對粘菌素敏感。而粘菌素是一種毒性很大的抗生素,會造成腎功能損害。甚至有些細菌對粘菌素也產生了耐藥性,對這些細菌真的是接近無藥可治了。細菌不斷突變的同時,新型抗菌藥物越來越少,人類在對細菌的戰爭中日益陷入尷尬的境地。
 碳青黴烯類耐藥肺炎克雷伯菌
碳青黴烯類耐藥肺炎克雷伯菌3、製藥公司已經基本放棄了對抗菌藥物研發的投入。首先發現新的抗生素已經變得極其困難,因為容易發現的藥物早已被發現了。其次,抗菌藥物能徹底治癒感染性疾病,製藥企業其實不喜歡這樣。他們寧願去開發降血脂藥、抗抑鬱藥這些需要長期服用的藥物,銷售額的增長才是公司的最終目標。
4、開發中國家在抗菌藥物研究中存在種種問題。比如難以實施臨床試驗、有效性的標準不一致等等。雖然這些只是抗菌藥物發展緩慢的部分原因,不過很遺憾,細菌耐藥性問題的日益嚴重造成了新型抗菌藥物的缺口。
5、醫院是超級細菌感染的重災區,醫院里有病人而很多病人往往需要使用抗菌藥物治療感染。其中不可避免會出現濫用抗生素的情況。醫院裡的病人很多是免疫功能低下的,比如接受化療或器官移植的病人,另一個原因就是醫院的人口密度大,就算防護措施做得很好,也不可能阻斷所有傳播途徑。
